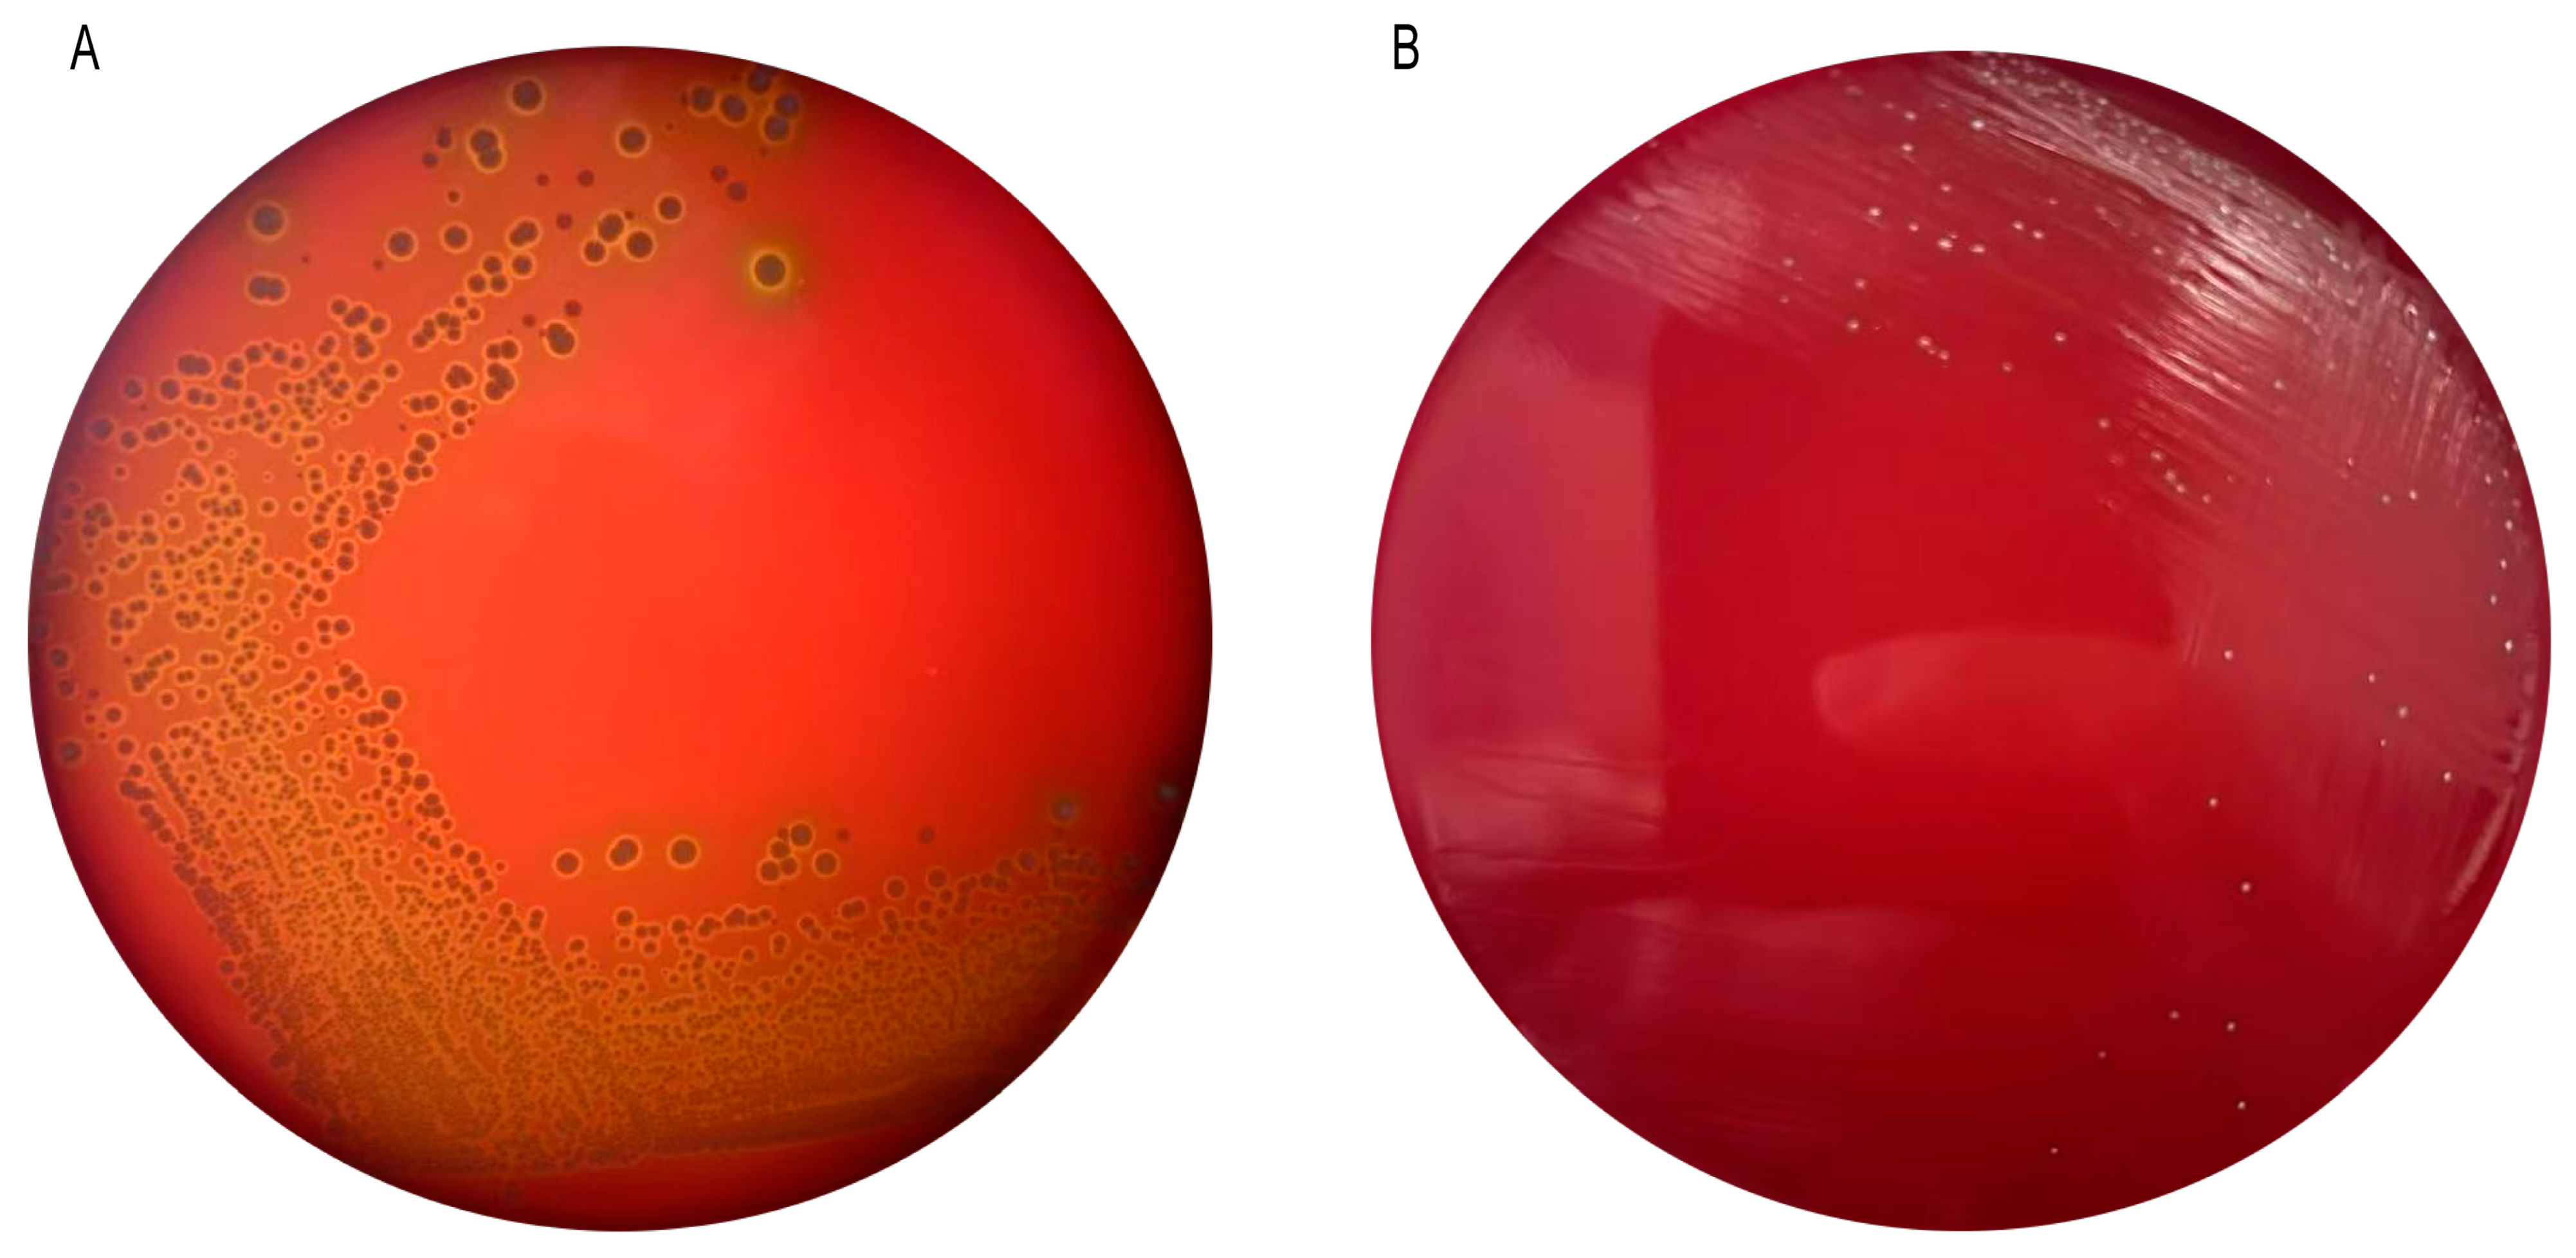
Microorganisms 13 00957 g003

Probiotic Potential of Pediococcus pentosaceus M6 Isolated from Equines and Its Alleviating Effect on DSS-Induced Colitis in Mice
Abstract
:1. Introduction
2. Materials and Methods
2.1. Screening and Identification of Equine-Derived Strains
2.1.1. Primary Screening
2.1.2. Re-Screening
2.2. DNA Extraction and 16S rDNA-Based Gene Amplification
2.3. Determination of Growth Performance of Pediococcus pentosaceus M6
2.4. Determination of Heat Resistance, Acid Resistance, and Bile Salt Resistance of Pediococcus pentosaceus M6
2.4.1. Determination of Heat Resistance
2.4.2. Determination of Acid Resistance
2.4.3. Determination of Bile Salt Resistance
2.5. Test of Simulated Artificial Gastric Juice, Intestinal Juice, and Self-Agglutination Ability
2.5.1. Simulated Artificial Gastric Juice Test
2.5.2. Simulated Artificial Intestinal Juice Test
2.5.3. Self-Agglutination Ability Test
2.6. Evaluation of the Probiotic Effect of Pediococcus pentosaceus M6
2.6.1. Hemolytic Test
2.6.2. Antimicrobial Activity Determination
2.6.3. Antibiotic Sensitivity Test
2.7. Therapeutic Effect of Pediococcus pentosaceus M6 on DSS-Induced Colitis in Mice
2.7.1. Analysis of Clinical Indexes
2.7.2. Histopathological Analysis
2.7.3. Detection of Inflammatory Cytokines in Serum
2.7.4. Gene Expression Analysis
2.8. Gut Microbiota Determination
2.9. Statistics and Analysis of Data
3. Results
3.1. Screening and Identification of Equine-Derived Strains
3.2. Growth Curve and Heat, Acid, and Bile Salt Resistance of Pediococcus pentosaceus M6
3.3. Self-Agglutination Ability and Tolerance to Gastric and Intestinal Fluids of Pediococcus pentosaceus M6
3.4. Hemolytic Properties of Pediococcus pentosaceus M6
3.5. Bacteriostatic Properties of Pediococcus pentosaceus M6
3.6. Antibiotic Susceptibility of Pediococcus pentosaceus M6
3.7. Analysis of the Therapeutic Results of Pediococcus pentosaceus M6 in DSS-Induced Colitis
3.7.1. Analysis of Results of Clinical Indices
3.7.2. Histopathological Observations
3.7.3. Serum Inflammatory Cytokine Levels
3.7.4. Gene Expression Results
3.8. Effect of Pediococcus pentosaceus M6 on the Intestinal Flora of Mice with Ulcerative Colitis
3.8.1. Analysis of Fecal Flora Diversity
3.8.2. Structure and Differential Analysis of Fecal Flora
4. Discussion
4.1. Screening and Characterization of Strains
4.2. Biofunctional Studies of Pediococcus pentosaceus M6
4.3. Probiotic Effects of Pediococcus pentosaceus M6
4.4. Analysis of the Therapeutic Results of M6 Strains in DSS-Induced Colitis in Mice
4.5. Effects of M6 Strain on Gut Microbiota in DSS-Induced Colitis Mice
5. Conclusions
Supplementary Materials
Author Contributions
Funding
Institutional Review Board Statement
Informed Consent Statement
Data Availability Statement
Acknowledgments
Conflicts of Interest
References
- Bruner, L.P.; White, A.M.; Proksell, S. Inflammatory Bowel Disease. Prim. Care 2023, 50, 411–427. [Google Scholar] [CrossRef] [PubMed]
- Liu, D.; Saikam, V.; Skrada, K.A.; Merlin, D.; Iyer, S.S. Inflammatory bowel disease biomarkers. Med. Res. Rev. 2022, 42, 1856–1887. [Google Scholar] [CrossRef] [PubMed]
- Hashimoto-Hill, S.; Alenghat, T. Inflammation-Associated Microbiota Composition Across Domestic Animals. Front. Genet. 2021, 12, 649599. [Google Scholar] [CrossRef] [PubMed]
- Uzal, F.A.; Arroyo, L.G.; Navarro, M.A.; Gomez, D.E.; Asín, J.; Henderson, E. Bacterial and viral enterocolitis in horses: A review. J. Vet. Diagn. Investig. 2022, 34, 354–375. [Google Scholar] [CrossRef]
- Qian, S.; Zhang, X.; Zheng, X.; Li, R.; Hao, X.; Tang, Z.; Yang, Z.; Sun, A.; Guo, S.; Song, Y.; et al. Development of interleukin-27 recombinant Lactococcus lactis and its efficacy in treating psoriasis and colitis in mice. Int. J. Biol. Macromol. 2024, 30, 137113. [Google Scholar] [CrossRef]
- Zheng, J.; Wittouck, S.; Salvetti, E.; Franz, C.M.A.P.; Harris, H.M.B.; Mattarelli, P.; O’Toole, P.W.; Pot, B.; Vandamme, P.; Walter, J.; et al. A taxonomic note on the genus Lactobacillus: Description of 23 novel genera, emended description of the genus Lactobacillus Beijerinck 1901, and union of Lactobacillaceae and Leuconostocaceae. Int. J. Syst. Evol. Microbiol. 2020, 70, 2782–2858. [Google Scholar] [CrossRef]
- Elhalik, M.A.; Mekky, A.E.; Khedr, M.; Suleiman, W.B. Antineoplastic with DNA fragmentation assay and anti-oxidant, anti-inflammatory with gene expression activity of Lactobacillus plantarum isolated from local Egyptian milk products. BMC Microbiol. 2024, 24, 443. [Google Scholar] [CrossRef]
- de Moreno de LeBlanc, A.; Del Carmen, S.; Chatel, J.M.; Miyoshi, A.; Azevedo, V.; Langella, P.; Bermúdez-Humarán, L.G.; LeBlanc, J.G. Current Review of Genetically Modified Lactic acid bacteria for the Prevention and Treatment of Colitis Using Murine Models. Gastroenterol. Res. Pract. 2015, 2015, 146972. [Google Scholar] [CrossRef]
- Lee, M.; Bang, W.Y.; Lee, H.B.; Yang, S.Y.; Lee, K.S.; Kang, H.J.; Hong, S.M.; Yang, J. Safety Assessment and Evaluation of Probiotic Potential of Lactobacillus bulgaricus IDCC 3601 for Human Use. Microorganisms 2024, 12, 2063. [Google Scholar] [CrossRef]
- Zhang, J.; Xiao, Y.; Wang, H.; Zhang, H.; Chen, W.; Lu, W. Lactic acid bacteria-derived exopolysaccharide: Formation, immunomodulatory ability, health effects, and structure-function relationship. Microbiol. Res. 2023, 274, 127432. [Google Scholar] [CrossRef]
- Garbacz, K. Anticancer activity of Lactic acid bacteria. Semin. Cancer Biol. 2022, 86 Pt 3, 356–366. [Google Scholar] [CrossRef]
- Lv, L.X.; Li, Y.D.; Hu, X.J.; Shi, H.Y.; Li, L.J. Whole-genome sequence assembly of Pediococcus pentosaceus LI05 (CGMCC 7049) from the human gastrointestinal tract and comparative analysis with representative sequences from three food-borne strains. Gut Pathog. 2014, 6, 36. [Google Scholar] [CrossRef]
- Pan, S.; Wei, H.; Yuan, S.; Kong, Y.; Yang, H.; Zhang, Y.; Cui, X.; Chen, W.; Liu, J.; Zhang, Y. Probiotic Pediococcus pentosaceus ameliorates MPTP-induced oxidative stress via regulating the Gut microbiota-gut-brain axis. Front. Cell Infect. Microbiol. 2022, 12, 1022879. [Google Scholar] [CrossRef] [PubMed]
- Qi, Y.; Huang, L.; Zeng, Y.; Li, W.; Zhou, D.; Xie, J.; Xie, J.; Tu, Q.; Deng, D.; Yin, J. Pediococcus pentosaceus: Screening and Application as Probiotics in Food Processing. Front. Microbiol. 2021, 12, 762467. [Google Scholar] [CrossRef]
- Qin, S.; Huang, Z.; Wang, Y.; Pei, L.; Shen, Y. Probiotic potential of Lactobacillus isolated from horses and its therapeutic effect on DSS-induced colitis in mice. Microb. Pathog. 2022, 165, 105216. [Google Scholar] [CrossRef]
- Angmo, K.; Kumari, A.; Savitri; Bhalla, T.C. Probiotic characterization of Lactic acid bacteria isolated from fermented foods and beverage of Ladakh. Food Sci. Technol. 2016, 66, 428–435. [Google Scholar] [CrossRef]
- Uezen, J.D.; Ficoseco, C.A.; Fátima Nader-Macías, M.E.; Vignolo, G.M. Identification and characterization of potential probiotic Lactic acid bacteria isolated from pig feces at various production stages. Can. J. Vet. Res. 2023, 87, 127–145. [Google Scholar] [PubMed]
- Lei, J.; Ran, X.; Guo, M.; Liu, J.; Yang, F.; Chen, D. Screening, Identification, and Probiotic Properties of Bacillus pumilus from Yak. Probiotics Antimicrob. Proteins 2024, 16, 531–540. [Google Scholar] [CrossRef]
- Liang, H.; Tran, N.T.; Deng, T.; Li, J.; Lei, Y.; Bakky, M.A.H.; Zhang, M.; Li, R.; Chen, W.; Zhang, Y.; et al. Identification and Characterization of a Potential Probiotic, Clostridium butyricum G13, Isolated from the Intestine of the Mud crab (Scylla paramamosain). Microbiol. Spectr. 2023, 11, e0131723. [Google Scholar] [CrossRef]
- Chin, C.S.; Peluso, P.; Sedlazeck, F.J.; Nattestad, M.; Concepcion, G.T.; Clum, A.; Dunn, C.; O’Malley, R.; Figueroa-Balderas, R.; Morales-Cruz, A.; et al. Phased diploid genome assembly with single-molecule real-time sequencing. Nat. Methods 2016, 13, 1050–1054. [Google Scholar] [CrossRef]
- Rako, A.; Kalit, M.T.; Rako, Z.; Zamberlin, Š.; Kalit, S. Contribution of salt content to the ripening process of Croatian hard sheep milk cheese (Brač cheese). LWT 2022, 162, 113506. [Google Scholar] [CrossRef]
- Huang, M.; Li, X.; Wu, Y.; Meng, X.; Tong, P.; Yuan, J.; Yang, A.; Wu, Z.; Chen, H.; Xiong, C. Potential allergenicity and hydrolysis assessment of bovine casein and β-casein by treatment with Lactic acid bacteria. J. Food Biochem. 2022, 46, e14424. [Google Scholar] [CrossRef] [PubMed]
- Sousa, A.M.; Machado, I.; Nicolau, A.; Pereira, M.O. Improvements on colony morphology identification towards bacterial profiling. J. Microbiol. Methods 2013, 95, 327–335. [Google Scholar] [CrossRef] [PubMed]
- Taye, Y.; Degu, T.; Fesseha, H.; Mathewos, M. Isolation and Identification of Lactic acid bacteria from Cow Milk and Milk Products. Sci. World J. 2021, 2021, 4697445. [Google Scholar] [CrossRef]
- Zhang, F.; Zhou, K.; Xie, F.; Zhao, Q. Screening and identification of Lactic acid bacteria with antimicrobial abilities for aquaculture pathogens in vitro. Arch. Microbiol. 2022, 204, 689. [Google Scholar] [CrossRef]
- Pasolli, E.; De Filippis, F.; Mauriello, I.E.; Cumbo, F.; Walsh, A.M.; Leech, J.; Cotter, P.D.; Segata, N.; Ercolini, D. Large-scale genome-wide analysis links Lactic acid bacteria from food with the gut microbiome. Nat. Commun. 2020, 11, 2610. [Google Scholar] [CrossRef]
- Sun, L.; Bai, C.; Xu, H.; Na, N.; Jiang, Y.; Yin, G.; Liu, S.; Xue, Y. Succession of Bacterial Community During the Initial Aerobic, Intense Fermentation, and Stable Phases of Whole-Plant Corn Silages Treated With Lactic acid bacteria Suspensions Prepared From Other Silages. Front. Microbiol. 2021, 12, 655095. [Google Scholar] [CrossRef] [PubMed]
- Hwanhlem, N.; Salaipeth, L.; Charoensook, R.; Kanjan, P.; Maneerat, S. Lactic acid bacteria from Gamecock and Goat Originating from Phitsanulok, Thailand: Isolation, Identification, Technological Properties and Probiotic Potential. J. Microbiol. Biotechnol. 2022, 32, 355–364. [Google Scholar] [CrossRef]
- Shao, Y.; Wu, X.; Yu, Z.; Li, M.; Sheng, T.; Wang, Z.; Tu, J.; Song, X.; Qi, K. Gut Microbiome Analysis and Screening of Lactic acid bacteria with Probiotic Potential in Anhui Swine. Animals 2023, 13, 3812. [Google Scholar] [CrossRef]
- Gunzburg, W.H.; Aung, M.M.; Toa, P.; Ng, S.; Read, E.; Tan, W.J.; Brandtner, E.M.; Dangerfield, J.; Salmons, B. Efficient protection of microorganisms for delivery to the intestinal tract by cellulose sulphate encapsulation. Microb. Cell Fact. 2020, 19, 216. [Google Scholar] [CrossRef]
- Murray, M.J.; Grodinsky, C. Regional gastric pH measurement in horses and foals. Equine Vet. J. Suppl. 1989, 21, 73–76. [Google Scholar] [CrossRef]
- Reuben, R.C.; Roy, P.C.; Sarkar, S.L.; Alam, R.U.; Jahid, I.K. Isolation, characterization, and assessment of Lactic acid bacteria toward their selection as poultry probiotics. BMC Microbiol. 2019, 19, 253. [Google Scholar] [CrossRef]
- Khusro, A.; Arasu, M.V.; Sahibzada, M.U.K.; Salem, A.Z.M.; Al-Dhabi, N.A.; Rivas-Caceres, R.R.; Seidel, V.; Choi, K.C. Assessment on In Vitro Probiotic Attributes of Lactobacillus plantarum Isolated From Horse Feces. J. Equine Vet. Sci. 2021, 107, 103769. [Google Scholar] [CrossRef] [PubMed]
- Diguță, C.F.; Nițoi, G.D.; Matei, F.; Luță, G.; Cornea, C.P. The Biotechnological Potential of Pediococcus spp. Isolated from Kombucha Microbial Consortium. Foods 2020, 9, 1780. [Google Scholar] [CrossRef] [PubMed]
- Shokryazdan, P.; Sieo, C.C.; Kalavathy, R.; Liang, J.B.; Alitheen, N.B.; Faseleh, J.M.; Ho, Y.W. Probiotic potential of Lactobacillus strains with antimicrobial activity against some human pathogenic strains. Biomed. Res. Int. 2014, 2014, 927268. [Google Scholar] [CrossRef]
- Kang, W.; Pan, L.; Peng, C.; Dong, L.; Cao, S.; Cheng, H.; Wang, Y.; Zhang, C.; Gu, R.; Wang, J.; et al. Isolation and characterization of Lactic acid bacteria from human milk. J. Dairy Sci. 2020, 103, 9980–9991. [Google Scholar] [CrossRef] [PubMed]
- Dos, S.L.E.; Ginani, V.C.; de Alencar, E.R.; Pereira, O.G.; Rose, E.C.P.; do Vale, H.M.M.; Pratesi, R.; Hecht, M.M.; Cavalcanti, M.H.; Tavares, C.S.O. Isolation, Identification, and Screening of Lactic acid bacteria with Probiotic Potential in Silage of Different Species of Forage Plants, Cocoa Beans, and Artisanal Salami. Probiotics Antimicrob. Proteins 2021, 13, 173–186. [Google Scholar]
- Allen, I.C.; Wilson, J.E.; Schneider, M.; Lich, J.D.; Roberts, R.A.; Arthur, J.C.; Woodford, R.M.; Davis, B.K.; Uronis, J.M.; Herfarth, H.H.; et al. NLRP12 suppresses colon inflammation and tumorigenesis through the negative regulation of noncanonical NF-κB signaling. Immunity 2012, 36, 742–754. [Google Scholar] [CrossRef]
- El Sayed, N.S.; Sayed, A.S. Protective effect of methylene blue on TNBS-induced colitis in rats mediated through the modulation of inflammatory and apoptotic signalling pathways. Arch. Toxicol. 2019, 93, 2927–2942. [Google Scholar] [CrossRef]
- Neurath, M.F. Strategies for targeting cytokines in inflammatory bowel disease. Nat. Rev. Immunol. 2024, 24, 559–576. [Google Scholar] [CrossRef]
- Tatiya-Aphiradee, N.; Chatuphonprasert, W.; Jarukamjorn, K. Immune response and inflammatory pathway of ulcerative colitis. J. Basic Clin. Physiol. Pharmacol. 2018, 30, 1–10. [Google Scholar] [CrossRef]
- Guo, W.; Mao, B.; Tang, X.; Zhang, Q.; Zhao, J.; Cui, S.; Zhang, H. Lactobacillus paracasei CCFM1223 Protects against Lipopolysaccharide-Induced Acute Liver Injury in Mice by Regulating the “Gut-Liver” Axis. Microorganisms 2022, 10, 1321. [Google Scholar] [CrossRef] [PubMed]
- Guo, W.; Mao, B.; Cui, S.; Tang, X.; Zhang, Q.; Zhao, J.; Zhang, H. Protective Effects of a Novel Probiotic Bifidobacterium pseudolongum on the Intestinal Barrier of Colitis Mice via Modulating the Pparγ/STAT3 Pathway and Intestinal Microbiota. Foods 2022, 11, 1551. [Google Scholar] [CrossRef] [PubMed]
- Zhang, Y.; Wu, Z.; Liu, J.; Zheng, Z.; Li, Q.; Wang, H.; Chen, Z.; Wang, K. Identification of the core active structure of a Dendrobium officinale polysaccharide and its protective effect against dextran sulfate sodium-induced colitis via alleviating Gut microbiota dysbiosis. Food Res. Int. 2020, 137, 109641. [Google Scholar] [CrossRef] [PubMed]
- Fang, C.; Cheng, J.; Jia, W.; Xu, Y. Akkermansia muciniphila Ameliorates Alcoholic Liver Disease in Experimental Mice by Regulating Serum Metabolism and Improving Gut Dysbiosis. Metabolites 2023, 13, 1057. [Google Scholar] [CrossRef]
- Li, Z.; Wang, K.; Ji, X.; Wang, H.; Zhang, Y. ACE2 suppresses the inflammatory response in LPS-induced porcine intestinal epithelial cells via regulating the NF-κB and MAPK pathways. Peptides 2022, 149, 170717. [Google Scholar] [CrossRef]
- Kim, J.H.; Won, Y.S.; Cho, H.D.; Hong, S.M.; Moon, K.D.; Seo, K.I. Protective Effect of Prunus mume Fermented with Mixed Lactic acid bacteria in Dextran Sodium Sulfate-Induced Colitis. Foods 2020, 10, 58. [Google Scholar] [CrossRef]
- Kuo, W.T.; Zuo, L.; Odenwald, M.A.; Madha, S.; Singh, G.; Gurniak, C.B.; Abraham, C.; Turner, J.R. The Tight Junction Protein ZO-1 Is Dispensable for Barrier Function but Critical for Effective Mucosal Repair. Gastroenterology 2021, 161, 1924–1939. [Google Scholar] [CrossRef]
- Segui-Perez, C.; Stapels, D.A.C.; Ma, Z.; Su, J.; Passchier, E.; Westendorp, B.; Wubbolts, R.W.; Wu, W.; van Putten, J.P.M.; Strijbis, K. MUC13 negatively regulates tight junction proteins and intestinal epithelial barrier integrity via protein kinase C. J. Cell Sci. 2024, 137, jcs261468. [Google Scholar] [CrossRef]
- Mir, H.; Meena, A.S.; Chaudhry, K.K.; Shukla, P.K.; Gangwar, R.; Manda, B.; Padala, M.K.; Shen, L.; Turner, J.R.; Dietrich, P.; et al. Occludin deficiency promotes ethanol-induced disruption of colonic epithelial junctions, gut barrier dysfunction and liver damage in mice. Biochim. Biophys. Acta 2016, 1860, 765–774. [Google Scholar] [CrossRef]
- Kamada, N.; Seo, S.U.; Chen, G.Y.; Núñez, G. Role of the Gut microbiota in immunity and inflammatory disease. Nat. Rev. Immunol. 2013, 13, 321–335. [Google Scholar] [CrossRef] [PubMed]
- Guo, W.L.; Pan, Y.Y.; Li, L.; Li, T.T.; Liu, B.; Lv, X.C. Ethanol extract of Ganoderma lucidum ameliorates lipid metabolic disorders and modulates the Gut microbiota composition in high-fat diet fed rats. Food Funct. 2018, 9, 3419–3431. [Google Scholar] [CrossRef] [PubMed]
- Li, Q.; Wang, C.; Tang, C.; Li, N.; Li, J. Molecular-phylogenetic characterization of the microbiota in ulcerated and non-ulcerated regions in the patients with Crohn’s disease. PLoS ONE 2012, 7, e34939. [Google Scholar] [CrossRef] [PubMed]
- Vich, V.i.l.a.A.; Collij, V.; Sanna, S.; Sinha, T.; Imhann, F.; Bourgonje, A.R.; Mujagic, Z.; Jonkers, D.M.A.E.; Masclee, A.A.M.; Fu, J.; et al. Impact of commonly used drugs on the composition and metabolic function of the Gut microbiota. Nat. Commun. 2020, 11, 362. [Google Scholar] [CrossRef]
- Stojanov, S.; Berlec, A.; Štrukelj, B. The Influence of Probiotics on the Firmicutes/Bacteroidetes Ratio in the Treatment of Obesity and Inflammatory Bowel disease. Microorganisms 2020, 8, 1715. [Google Scholar] [CrossRef]
- Guo, W.L.; Chen, M.; Pan, W.L.; Zhang, Q.; Xu, J.X.; Lin, Y.C.; Li, L.; Liu, B.; Bai, W.D.; Zhang, Y.Y.; et al. Hypoglycemic and hypolipidemic mechanism of organic chromium derived from chelation of Grifola frondosa polysaccharide-chromium (III) and its modulation of intestinal microflora in high fat-diet and STZ-induced diabetic mice. Int. J. Biol. Macromol. 2020, 145, 1208–1218. [Google Scholar] [CrossRef]
- Li, H.; Cao, W.; Xie, J.; Che, H.; Liu, L.; Dong, X.; Song, L.; Xie, W. α-D-1,6-glucan from Castanea mollissima Blume alleviates dextran sulfate sodium-induced colitis in vivo. Carbohydr. Polym. 2022, 289, 119410. [Google Scholar] [CrossRef]
- Lee, K.S.; Palatinszky, M.; Pereira, F.C.; Nguyen, J.; Fernandez, V.I.; Mueller, A.J.; Menolascina, F.; Daims, H.; Berry, D.; Wagner, M.; et al. An automated Raman-based platform for the sorting of live cells by functional properties. Nat. Microbiol. 2019, 4, 1035–1048. [Google Scholar] [CrossRef]
- Evans, C.C.; LePard, K.J.; Kwak, J.W.; Stancukas, M.C.; Laskowski, S.; Dougherty, J.; Moulton, L.; Glawe, A.; Wang, Y.; Leone, V.; et al. Exercise prevents weight gain and alters the Gut microbiota in a mouse model of high fat diet-induced obesity. PLoS ONE 2014, 9, e92193. [Google Scholar] [CrossRef]
- Huang, W.; Ma, T.; Liu, Y.; Kwok, L.Y.; Li, Y.; Jin, H.; Zhao, F.; Shen, X.; Shi, X.; Sun, Z.; et al. Spraying compound probiotics improves growth performance and immunity and modulates Gut microbiota and blood metabolites of suckling piglets. Sci. China Life Sci. 2023, 66, 1092–1107. [Google Scholar] [CrossRef]

| Project | Result | Project | Result |
|---|---|---|---|
| Esculin hydrate | − | Power | + |
| D(+)-cellobiose | + | H2S | − |
| Maltose | + | Indole | − |
| Mannitol | + | H2O2 | − |
| D(−)-salicin | + | Gelatin starch hydrolysis | + |
| Sorbitol | − | Nitrate | + |
| Sucrose | + | V-p | − |
| Raffinose | + | Mr | + |
| Inulin | − | Glucose gas production | + |
| Lactose | − | 1% sodium hippuric acid | − |
| Time, h | Gastric Fluid Survival Rate, % | Intestinal Fluid Survival Rate, % |
|---|---|---|
| 0 | 100 | 100 |
| 3 | 8.99 ± 0.47 | 4.77 ± 0.58 |
| Pathogenic Bacteria | Inhibitory Circle Diameter (mm) |
|---|---|
| Escherichia coli | 9.50 ± 0.69 |
| Salmonella | 16.71 ± 0.67 |
| Staphylococcus aureus | 14.29 ± 0.69 |
| Antibiotics | Sensitivities | Antibiotics | Sensitivities |
|---|---|---|---|
| Penicillin | +++ | Neomycin | − |
| Oxacillin | + | Achromycin | ++ |
| Carbenicillin | +++ | Deoxytetracycline | ++ |
| Ampicillin | ++ | Minocycline | − |
| Piperacillin | ++ | Erythromycin | ++ |
| Cefalexin | − | Midecamycin | +++ |
| Cefazolin | + | Norfloxacin fluoride | − |
| Cefradine | + | Norfloxacin | − |
| Cefuroxime | + | Ciprofloxacin | − |
| Ceftazidime | ++ | Vancomycin | − |
| Ceftriaxone | − | Polyglycosamicin | − |
| Cefoperazone | ++ | Bactrim | − |
| Butylamine kaner | ++ | Foroxone | ++ |
| Gentamicin | − | Clindamycin | ++ |
| Kanamycin | − | Amchloromycin | +++ |
Disclaimer/Publisher’s Note: The statements, opinions and data contained in all publications are solely those of the individual author(s) and contributor(s) and not of MDPI and/or the editor(s). MDPI and/or the editor(s) disclaim responsibility for any injury to people or property resulting from any ideas, methods, instructions or products referred to in the content. |
© 2025 by the authors. Licensee MDPI, Basel, Switzerland. This article is an open access article distributed under the terms and conditions of the Creative Commons Attribution (CC BY) license (https://creativecommons.org/licenses/by/4.0/).
Share and Cite
Cao, J.; Zhang, J.; Wu, H.; Lin, Y.; Fang, X.; Yun, S.; Du, M.; Su, S.; Liu, Y.; Wang, N.; et al. Probiotic Potential of Pediococcus pentosaceus M6 Isolated from Equines and Its Alleviating Effect on DSS-Induced Colitis in Mice. Microorganisms 2025, 13, 957. https://doi.org/10.3390/microorganisms13050957
Cao J, Zhang J, Wu H, Lin Y, Fang X, Yun S, Du M, Su S, Liu Y, Wang N, et al. Probiotic Potential of Pediococcus pentosaceus M6 Isolated from Equines and Its Alleviating Effect on DSS-Induced Colitis in Mice. Microorganisms. 2025; 13(5):957. https://doi.org/10.3390/microorganisms13050957
Chicago/Turabian StyleCao, Jialong, Jianqiang Zhang, Hui Wu, Yanan Lin, Xinlan Fang, Siqin Yun, Ming Du, Shaofeng Su, Yuanyi Liu, Na Wang, and et al. 2025. "Probiotic Potential of Pediococcus pentosaceus M6 Isolated from Equines and Its Alleviating Effect on DSS-Induced Colitis in Mice" Microorganisms 13, no. 5: 957. https://doi.org/10.3390/microorganisms13050957
APA StyleCao, J., Zhang, J., Wu, H., Lin, Y., Fang, X., Yun, S., Du, M., Su, S., Liu, Y., Wang, N., Bao, T., Bai, D., & Zhao, Y. (2025). Probiotic Potential of Pediococcus pentosaceus M6 Isolated from Equines and Its Alleviating Effect on DSS-Induced Colitis in Mice. Microorganisms, 13(5), 957. https://doi.org/10.3390/microorganisms13050957






